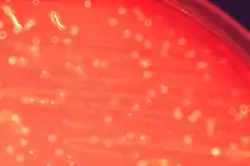

| Streptococcus anginosus | ||
|---|---|---|
![]() Colonias de S. anginosus | ||
| Taxonomía | ||
| Dominio: | Bacteria | |
| Filo: | Bacillota | |
| Clase: | Bacilli | |
| Orden: | Lactobacillales | |
| Familia: | Streptococcaceae | |
| Género: | Streptococcus | |
| Especie: |
Streptococcus anginosus (Andrewes & Horder 1906) Smith & Sherman 1938 | |
Streptococcus anginosus es una especie de bacteria de la familia Streptococcaceae.[1] Junto con S. constellatus y S. intermedius forma parte de los estreptococos del grupo anginosus, por su relación filogenética.[2]
Es un componente de la microbiota normal de la cavidad oral, garganta, tracto gastrointestinal y aparato genitourinario, pero también es capaz de causar enfermedad en varias localizaciones.[3]
Subespecies
A fecha de 2022, existen dos subespecies descritas:[1][2]
- Streptococcus anginosus subsp. anginosus (Andrewes & Horder 1906) Jensen et al. 2013
- Streptococcus anginosus subsp. whileyi Jensen et al. 2013
Referencias
- 1 2 Parte, A. C. «Species Streptococcus anginosus». LPSN (en inglés). Consultado el 14 de diciembre de 2022.
- 1 2 Jensen, Anders; Hoshino, Tomonori; Kilian, Mogens (1 de julio de 2013). «Taxonomy of the Anginosus group of the genus Streptococcus and description of Streptococcus anginosus subsp. whileyi subsp. nov. and Streptococcus constellatus subsp. viborgensis subsp. nov.». International Journal of Systematic and Evolutionary Microbiology (en inglés) 63 (Pt_7): 2506-2519. PMID 23223817. doi:10.1099/ijs.0.043232-0. Consultado el 14 de diciembre de 2022.
- ↑ Pilarczyk-Zurek, Magdalena; Sitkiewicz, Izabela; Koziel, Joanna (8 de julio de 2022). «The Clinical View on Streptococcus anginosus Group – Opportunistic Pathogens Coming Out of Hiding». Frontiers in Microbiology (en inglés) 13: 956677. PMC 9309248. PMID 35898914. doi:10.3389/fmicb.2022.956677. Consultado el 14 de diciembre de 2022.
Este artículo ha sido escrito por Wikipedia. El texto está disponible bajo la licencia Creative Commons - Atribución - CompartirIgual. Pueden aplicarse cláusulas adicionales a los archivos multimedia.